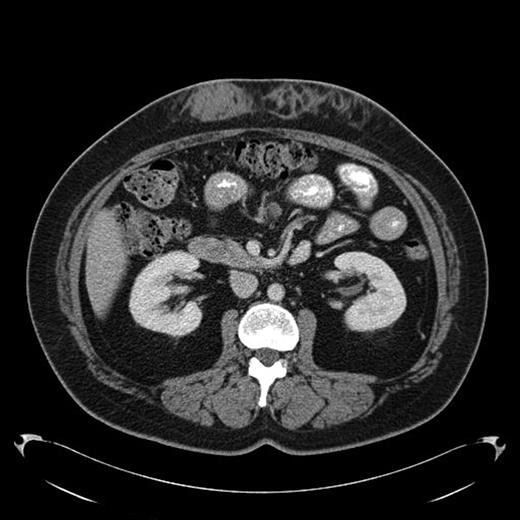
Fig 1. Amyloid infiltration in subcutaneous tissue of upper abdomen at insulin injection site

Abstract
Abstract 4908
Insulin resistance can be a major problem in patients with diabetes mellitus. Although multiple reasons can result in this problem, one of the rare causes is localized insulin induced cutaneous amyloidosis. Lack of recognition of this may result in fatal hypoglycemia if a higher dose of insulin is given at a different site.
A 43-year-old female diagnosed with diabetes mellitus in 1986 after acute pancreatitis secondary to hypertriglyceridemia presented to our hospital in December of 2008 with a 2 year history of low grade fever of 99-100F. This was associated with chills and fatigue. Over the same time period she had noticed anterior abdominal wall nodularity, particularly at sites where she has been injecting her insulin. Her insulin requirement had also increased from a total of 60 units of NPH in a day to 170 units per day. Because of the subcutaneous nodularity at the site of injection a decision was made to switch the site of the insulin which resulted in lower blood glucose level and subsequently significant decrease in her insulin requirement to 120 units a day. This suggested poor absorption from the infiltrated site. At our clinic laboratory data showed normal white count of 5.4 × 10(9)/L with normal differential, normal hemoglobin of 12.9 g/dL with an ESR of 11 mm/hour, creatinine of 0.8 mg/dL and C-reactive protein of less than 3. As part of the work up for fever of unknown origin a CT-scan of the abdomen was obtained which showed infiltrative lesion in the anterior abdominal subcutaneous tissue with few calcifications Fig 1 & 2. Biopsy of the anterior abdominal wall nodular infiltrate was performed. Tissue cultures came out negative for infection. The biopsy showed eosinophilic material positive with Congo red staining and showing apple green birefringence when viewed under polarized light. Immunohistochemical staining showed this to be negative for AA, AL, or TTR amyloidosis. Liquid chromatography tandem mass spectrometry (LC MS/MS) detected peptides representing apolipoprotein E, apolipoprotein A-IV, SAP and Insulin. The amyloid deposits stained positive with anti-insulin. The presence of peptides from insulin and immunohistochemical reactivity with an anti-insulin antibody indicated that the amyloid deposits were caused by insulin injection at this site. Work up for systemic amyloidosis including serum protein electrophoresis with immunofixation was negative for a monoclonal protein. Quantitative immunoglobulins were within normal range. Her 24-hour urine protein was 65 mg within normal range. Her serum free light chains were unremarkable. Echocardiogram did not show any evidence of infiltrative cardiomyopathy. This was therefore consistent with localized insulin induced cutaneous amyloidosis. The recommendation was to change the insulin type and to rotate the insulin injection site. Because of occasional hemorrhage and pain the long term plan will be to surgically remove the amyloid deposits.
Insulin mediated iatrogenic localized amyloidosis has been described previously in the literature at the sites of insulin injection in patients with diabetes. This is a rare complication of insulin therapy and must be considered in the differential diagnosis of patients with insulin resistance to prevent fatal hypoglycemia.
Amyloid infiltration in subcutaneous tissue of upper abdomen at insulin injection site
Amyloid infiltration in subcutaneous tissue of upper abdomen at insulin injection site
Amyloid infiltration in subcutaneous tissue of lower abdomen at insulin injection site
Amyloid infiltration in subcutaneous tissue of lower abdomen at insulin injection site
No relevant conflicts of interest to declare.
Author notes
Asterisk with author names denotes non-ASH members.

This feature is available to Subscribers Only
Sign In or Create an Account Close Modal